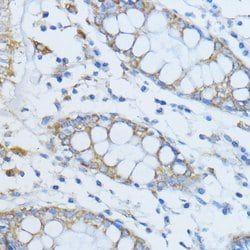
Img

PrP Polyclonal Antibody, Invitrogen™
Manufacturer: Thermo Scientific
Select a Size
| Pack Size | SKU | Availability | Price |
|---|---|---|---|
| Each of 1 | PIPA596175-Each-of-1 | In Stock | ₹ 46,502.50 |
PIPA596175 - Each of 1
In Stock
Quantity
1
Base Price: ₹ 46,502.50
GST (18%): ₹ 8,370.45
Total Price: ₹ 54,872.95
Antigen
PrP
Classification
Polyclonal
Conjugate
Unconjugated
Gene
PRNP
Gene Alias
AA960666, AI325101, Alternative prion protein, alternative prion protein, major prion protein, AltPrP, ASCR, BSE, CD230, CD230 antigen, CJD, GSS, KURU, major prion protein, major prion protein, alternative prion protein, major scrapie-associated fibril protein 1, MGC26679, p27-30, PK resistant core, prion protein, prion protein (p27-30) (Creutzfeldt-Jakob disease, Gerstmann-Strausler-Scheinker syndrome, fatal familial insomnia), prion protein precursor, prion protein precursor PrP, prion protein PrP, prion protein variant a, prion protein variant b, prion protein, PrP, prion protein, structural, prion-related protein, PRIP, Prn, Prn-i, Prnp, Prn-p, PrP, PrP<C>, PrP27-30, PrP33-35C, PrPc, PrPSc, Sinc, SIP, TSE
Host Species
Rabbit
Purification Method
Affinity Chromatography
Regulatory Status
RUO
Gene ID (Entrez)
19122, 5621
Content And Storage
-20° C, Avoid Freeze/Thaw Cycles
Form
Liquid
Applications
Western Blot
Concentration
0.45 mg/mL
Formulation
PBS with 50% glycerol and 0.02% sodium azide, pH 7.3
Gene Accession No.
F7VJQ1, P04156, P04925
Gene Symbols
PRNP
Immunogen
Recombinant fusion protein containing a sequence corresponding to amino acids 23-230 of human Prion Protein (NP_0010735921)
Quantity
100 μL
Primary or Secondary
Primary
Target Species
Human, Mouse
Product Type
Antibody
Isotype
IgG
Description
- Immunogen sequence: KKRPKPGGWN TGGSRYPGQG SPGGNRYPPQ GGGGWGQPHG GGWGQPHGGG WGQPHGGGWG QPHGGGWGQG GGTHSQWNKP SKPKTNMKHM AGAAAAGAVV GGLGGYMLGS AMSRPIIHFG SDYEDRYYRE NMHRYPNQVY YRPMDEYSNQ NNFVHDCVNI TIKQHTVTTT TKGENFTETD VKMMERVVEQ MCITQYERES QAYYQRGS; Positive Samples: Mouse brain; Cellular Location: Cell membrane, Cytoplasm, GPI-anchor, Golgi apparatus, Lipid-anchor, Nucleus Human prion protein (PrP), also known as PRNP, is a ubiquitously expressed GPI-anchored cell surface glycoprotein associating with lipid raft components and functioning as a signaling molecule
- PrP plays a role in apoptosis in a cell context-dependent manner, is involved in proliferation of epithelial cells and in distribution of junction-associated proteins in human enterocytes
- Conversion of this normal cellular prion protein (PrPc) into an abnormal conformer (PrPSc) is the crucial step associated with triggering the pathogenesis of the prion neurodegenerative disorders, such as the Creutzfeld-Jakob disease (CJD)
- Whereas PrPc is rich in alpha-helices, the PrPSc form has higher content of beta-sheets and is resistant to proteinase K.